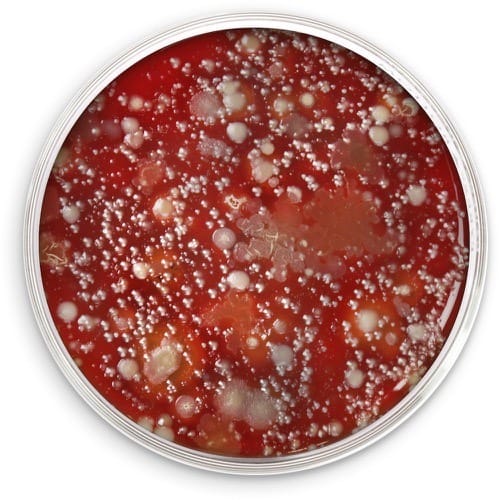
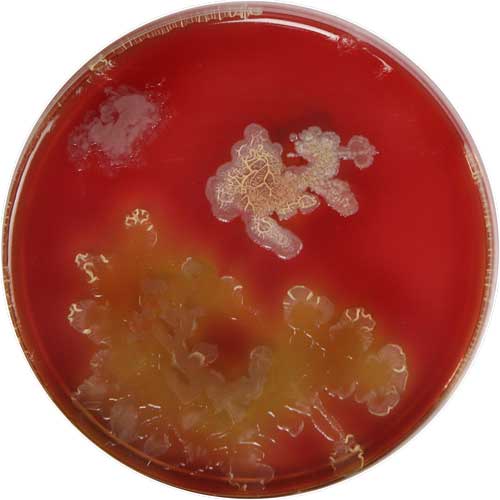
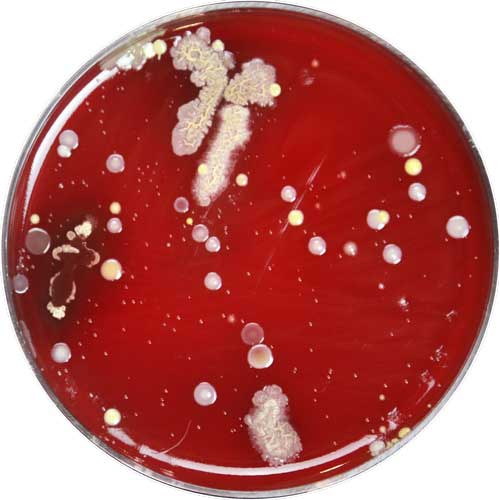
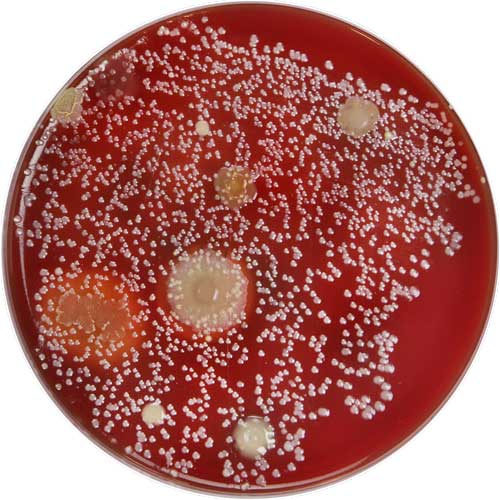

Why UV-C?
A cell phone has 18x more bacteria than a public restroom.
Toilet Handle
Phone

Toilet Handle
How does your phone get so dirty?
Whatever your hands touch, your phone collects.
Throughout the day, all the bacteria you touch on grocery carts, gas pumps, doorknobs, and even other people are transferred and stored on your phone.
The third hand
you never wash.
We wash our hands to stay
healthy, but not our phones.
A petri dish in your pocket.
Warm places like pockets and purses are breeding grounds for bacteria.
Our phones make us sick.
When we use our phones germs are transferred back to our hands, faces and everyday items like food.
Stay healthy
with PhoneSoap.
The best way to clean your phone.
PhoneSoap kills microorganisms that hide in crevices where cleaning wipes can’t reach.
Clinically proven results.
PhoneSoap’s powerful UV-C light is totally safe for electronics while killing 99.99%† of germs.
×


